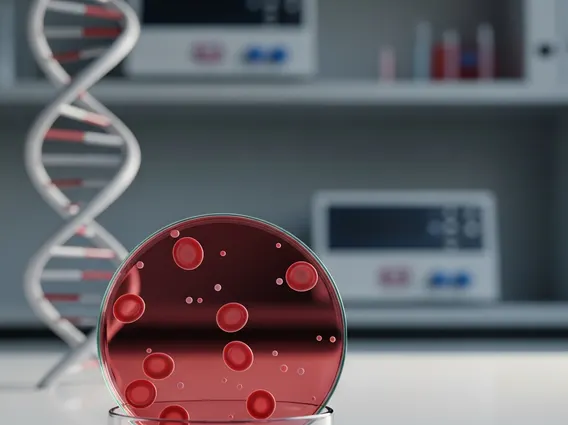

Idiopathic Thrombocytopenic Purpura
Idiopathic Thrombocytopenic Purpura (ITP) is an autoimmune bleeding disorder characterized by a low platelet count, which can lead to easy bruising and bleeding. Understanding this condition is crucial for effective management and improved quality of life.
Key Takeaways
- Idiopathic Thrombocytopenic Purpura (ITP) is an autoimmune disorder where the immune system mistakenly attacks and destroys platelets, leading to a reduced platelet count.
- Common ITP symptoms and causes include easy bruising, petechiae, nosebleeds, and gum bleeding, resulting from the accelerated destruction of platelets.
- Idiopathic thrombocytopenic purpura treatment aims to increase platelet counts and prevent serious bleeding, often involving corticosteroids, intravenous immunoglobulin, or other immunosuppressants.
- Living with ITP involves careful monitoring, lifestyle adjustments, and a strong support system to manage symptoms and maintain well-being.
What is Idiopathic Thrombocytopenic Purpura (ITP)?
Idiopathic Thrombocytopenic Purpura (ITP) is an autoimmune disorder in which the body’s immune system mistakenly attacks and destroys its own platelets. Platelets are essential blood cells that help stop bleeding by forming clots. When platelet counts fall too low, individuals may experience excessive bruising and bleeding. The term “idiopathic” indicates that the exact cause for this immune system malfunction is often unknown, though it can sometimes be triggered by infections or certain medications.
ITP can affect both children and adults, though it often presents differently in each group. In children, it frequently occurs after a viral infection and may resolve spontaneously. In adults, ITP is more likely to be chronic, requiring ongoing management. According to medical literature, the incidence of ITP is estimated to be 2-5 cases per 100,000 adults per year and 1-4 cases per 100,000 children per year, highlighting its prevalence as a significant hematological condition.
Recognizing ITP: Symptoms and Underlying Causes
Recognizing the signs of low platelet counts is vital for an early diagnosis of ITP. The primary ITP symptoms and causes stem from the body’s inability to form effective blood clots due to platelet deficiency. Symptoms can range from mild to severe and may include:
- Easy bruising, often appearing without obvious injury.
- Petechiae: small, pinpoint red or purple spots on the skin, typically on the lower legs, caused by bleeding under the skin.
- Nosebleeds that are frequent, prolonged, or difficult to stop.
- Bleeding from the gums, especially after brushing teeth.
- Blood in urine or stools.
- Unusually heavy menstrual periods in women.
- Fatigue, which can be a general symptom of chronic illness.
The underlying cause of ITP is an autoimmune response where antibodies produced by the immune system bind to platelets, marking them for destruction by macrophages, primarily in the spleen. This accelerated destruction leads to a reduced number of circulating platelets. While the trigger for this autoimmune response is often unknown, factors such as viral infections (e.g., HIV, hepatitis C), certain medications, or other autoimmune diseases can sometimes be associated with its onset.
Managing ITP: Treatment and Daily Life
The goal of idiopathic thrombocytopenic purpura treatment is to raise the platelet count to a safe level, thereby reducing the risk of significant bleeding, and to improve the patient’s quality of life. Treatment strategies vary depending on the severity of symptoms, the platelet count, and whether the condition is acute or chronic. Common treatments include:
Initial treatments often involve corticosteroids, such as prednisone, which suppress the immune system and reduce platelet destruction. Intravenous immunoglobulin (IVIG) may also be used, particularly in emergencies or when a rapid increase in platelet count is needed, as it temporarily blocks the immune system’s attack on platelets. For individuals who do not respond to initial therapies or have chronic ITP, other options may be considered. These can include thrombopoietin receptor agonists (TPO-RAs), which stimulate the bone marrow to produce more platelets, or rituximab, an antibody that targets certain immune cells. In some cases, surgical removal of the spleen (splenectomy) may be recommended, as the spleen is a primary site of platelet destruction.
Living with ITP involves more than just medical treatment; it requires careful self-management and lifestyle adjustments. Regular monitoring of platelet counts and symptoms is essential. Individuals with ITP are often advised to avoid activities that carry a high risk of injury, such as contact sports, to prevent bleeding. Over-the-counter medications that can interfere with platelet function, like aspirin and ibuprofen, should also be avoided unless specifically approved by a doctor. Emotional support and education about the condition are crucial for patients and their families to cope with the challenges of ITP. While alternative or complementary therapies may be discussed, it is important to remember that this information is supportive only and does not replace medical treatment or professional medical advice.



















